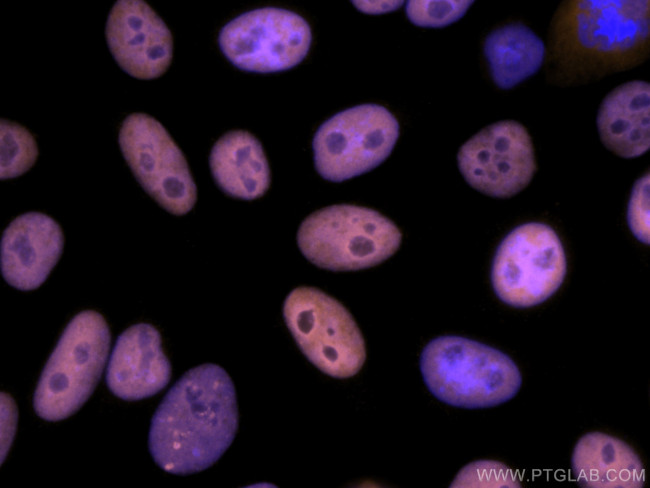
KAP1 Antibody in Immunocytochemistry (ICC/IF)

Search
Proteintech
KAP1 Monoclonal Antibody (1B9G12), CoraLite® 555
{{$productOrderCtrl.translations['antibody.pdp.commerceCard.promotion.promotions']}}
{{$productOrderCtrl.translations['antibody.pdp.commerceCard.promotion.viewpromo']}}
{{$productOrderCtrl.translations['antibody.pdp.commerceCard.promotion.promocode']}}: {{promo.promoCode}} {{promo.promoTitle}} {{promo.promoDescription}}. {{$productOrderCtrl.translations['antibody.pdp.commerceCard.promotion.learnmore']}}


Please note: We are reviewing Western blot images included in the antibody testing data in our catalog, including those provided by third parties. Unless expressly labeled or annotated as “raw-unedited”, Western blot images included in the antibody testing data in our catalog may have been edited, optimized or otherwise adjusted for presentation.
产品信息
CL55566630100UL
种属反应
宿主/亚型
分类
类型
克隆号
偶联物
激发/发射光谱
形式
浓度
规格
纯化类型
保存液
内含物
保存条件
运输条件
靶标信息
The KRAB (Kruppel-associated box) domain is about 45 amino acids in length and is a transcriptional repression domain found in numerous transcription factors. There have been identified over 220 KRAB-zinc finger protein (KRAB-ZFP) genes in the human genome. These proteins functionally repress transcription via specific interactions with KAP-1 (KRAB-associated protein 1). KAP-1 is an 835 amino acid polypeptide that contains a RING finger, B boxes, and a PHD finger. KAP-1 has been shown to form complexes with KRAB-domain transcription factors and increase the efficiency with which they mediate repression. KAP-1 has also been shown to directly interact with HP1 (heterochromatin protein 1) and KRAZ1 (Kruppel-associated box-containing zinc finger protein 1). KAP-1 directly targets KRAZ1 to the foci of centromeric heterochromatin containing HP1alpha, thus helping to regulate transcriptional repression. Studies have shown that KAP-1 mutants with the ability to bind KRAB but unable to bind HP1 leads to random distribution of KRAZ1 and strong transcriptional activation.
仅用于科研。不用于诊断过程。未经明确授权不得转售。
篇参考文献 (0)
生物信息学
蛋白别名: E3 SUMO-protein ligase TRIM28; KAP-1; KRAB-associated protein 1; KRAB-interacting p; KRAB-interacting protein 1; KRIP-1; Nuclear corepressor KAP-1; RING finger protein 96; RING-type E3 ubiquitin transferase TIF1-beta; tif1 beta; TIF1-beta; Transcription intermediary factor 1-beta; tripartite motif; Tripartite motif-containing protein 28
基因别名: KAP1; RNF96; TIF1B; TRIM28
Entrez Gene ID: (Human) 10155